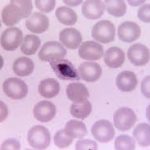
Parásitos que manipulan a otro organismo Ciencia y Medio Ambiente

Archives for Ciencia y Medio Ambiente - Page 23
La sanación a través de la respiración
Respirar bien para vivir mejor es una apertura al bienestar físico y mental que pide nuestra atención ante el mucho en el que convivimos. La respiración profunda nos beneficia respecto…
Historia de la penicilina ¿Qué es y cómo se descubrió?
Para iniciar es bueno dejar claro que la penicilina se encuentra en el grupo de antibióticos en el grupo de los betalactámicos; estos son empleamos profundamente gracias a los empleos…
¿Qué son los alimentos procesados?
La comida procesada incluye todos aquellos alimentos que sufren cambios a causa de su procesamiento industrial antes de llegar a nuestras manos para su consumo. Es gracias a ese procesamiento…
A qué se debe la explosión de las palomitas de maíz
Para nadie es un secreto que las palomitas de maíz son uno de los grandes aperitivos más populares para todo el mundo; el mismo ha recibido infinidad de nombres, como…
Parásitos que manipulan a otro organismo
La posibilidad de que un organismo manipule a otro no es única; de hecho es muy común de las películas de ciencia o de terror. De hecho, todo esto es…